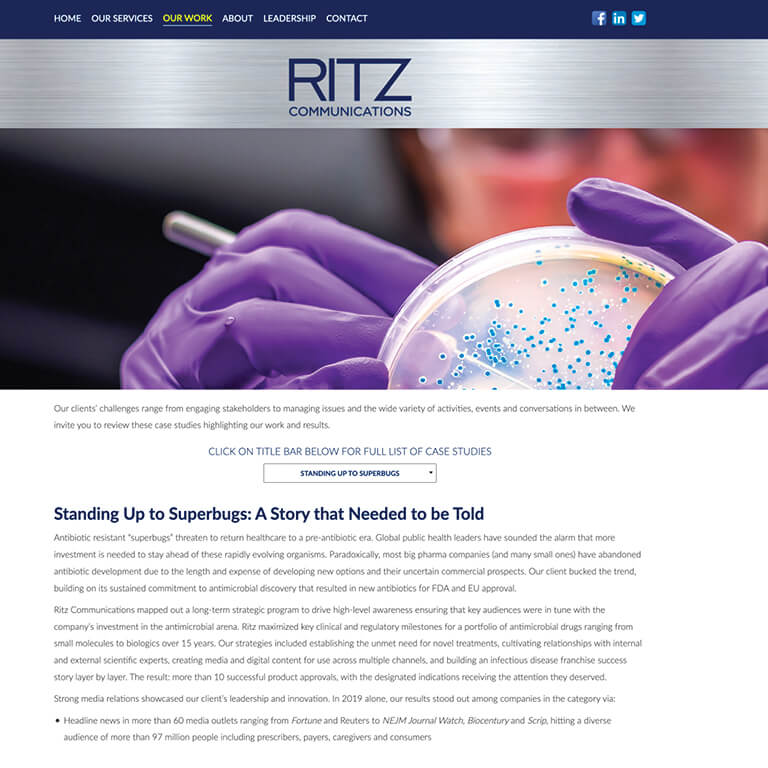

DOYENNE WEALTH ADVISORS
BRAND ENHANCEMENT, WEBSITE DESIGN/DEVELOPMENT
Doyenne Wealth Advisors provides customized wealth advisory services for high-net-worth individuals and families and has extensive expertise in multigenerational wealth planning. Doyenne’s goal is to empower their clients to live life fully; the measure of their success is not simply financial performance, but also their clients’ confidence and well-being.
RVP created their new website to effectively communicate how Doyenne strives to understand each client’s wishes, motivations, and attitudes regarding wealth, then develops an informed strategy tailored to their specific ambitions.
1500 LAKE SHORE DRIVE
BRAND IDENTITY DESIGN, WEBSITE DESIGN/DEVELOPMENT
1500 Lake Shore Drive is a cooperative residence and one of the most prestigious and desirable buildings in Chicago over its almost 90-year history.
RVP was hired to create a new brand identity and website in order to showcase the unrivaled and extraordinary service and personal attention 1500 provides to its shareholders, as well as create greater awareness about the building and its amenities to the real estate brokerage community.
LAUNCH TECHNICAL WORKFORCE SOLUTIONS
BRANDING, WEBSITE DESIGN/DEVELOPMENT, MARKETING COMMUNICATIONS, ADVERTISING
CLIENT TESTIMONIAL
“We have been working with RVP for more than five years. During that time our organization has grown tremendously and they have been a valued partner in assisting us in strengthening our brand, crafting our messages to various target audiences, enhancing awareness of our services, and creating communications that connect with our clients and employees.”
— MIKE GUAGENTI | CEO
PREVENT BLINDNESS
WEBSITE DESIGN/DEVELOPMENT
Prevent Blindness is the nation’s leading volunteer eye health and safety organization dedicated to fighting blindness and saving sight.
RVP was hired to redesign their website to support the organization’s new branding strategy. The redesign required improving navigation for enhanced usability as well as telling the story of Prevent Blindness more effectively. Improvements to site included enhancements to incorporate more video, audio and graphics as well as better integration of social media. The design was then adapted to the organization’s 12 affiliate sites.
RITZ COMMUNICATIONS
BRAND IDENTITY DESIGN, WEBSITE DESIGN/DEVELOPMENT
Ritz Communications is an independent, woman-owned public relations, marketing communications and branding firm specializing in healthcare. The agency’s innovative, results-oriented public relations programs support corporate and marketing goals, gain widespread media coverage, build reputations and brands and communicate health policy decisions.
RVP was hired to refresh the firm’s brand identity and create their new website. The site was designed to communicate the Ritz difference and provide prospective clients with a better understanding of the process and methodology that Ritz employees in their client engagements while showcasing a myriad of case studies that highlight client successes.
SAINT PATRICK HIGH SCHOOL
BRAND IDENTITY DESIGN, WEBSITE DESIGN DEVELOPMENT, MARKETING COMMUNICATIONS, ADVERTISING
CLIENT TESTIMONIAL
“With Robert Viola’s discovery process, everyone had a sense of ownership in the rebranding project from the beginning, and their enthusiasm grew as the new brand was introduced. Their buy in and excitement helped immeasurably. We’ve always had a great story to tell and now we’re doing it better than ever.”
— BROTHER KONRAD DIEBOLD | President Emeritus
JAIME GARCIA STYLE
BRAND IDENTITY DESIGN, WEBSITE DESIGN/DEVELOPMENT, MARKETING COMMUNICATIONS
More than three decades dedicated to artistry have provided Jaime with a distinctive point of view—focused on YOU. He brings his impeccable precision and unique vision to collaborate with you to define the best style to fit your lifestyle. Jaime’s instinctive approach to hair is inspired by his own passions for art, music, travel and food. And, he knows that each of us longs to find an outward expression of ourselves that we can wear comfortably and confidently to convey who we are.
LOWERY ASSET CONSULTING, LLC
BRAND IDENTITY DESIGN, WEBSITE DESIGN/DEVELOPMENT
CLIENT TESTIMONIAL
“Working with Robert Viola Partners on our branding and communications program has been a very efficient process. During the discovery phase they listened intently and designed the brand and communications that more clearly represent our philosophy and approach to investments. We are now able to present our capabilities more effectively and clearly articulate our points of differentiation. Our brand is much more powerful.”
— DOROTHY E. BOSSUNG | Executive Vice President
SUDLER PROPERTY MANAGEMENT
BRAND IDENTITY DESIGN, WEBSITE DESIGN/DEVELOPMENT, MARKETING COMMUNICATIONS
Sudler Property Management is one of Chicago’s finest property management companies because of their commitment to offering superior service to each and every client they serve. Their entire team is dedicated to delivering excellence in everything they do.
This focus results in a deep knowledge of the city and its resources, and an ability to lead the way in new thinking and approaches in property management. The Sudler brand and communications showcases their Chicago connection and highlights their commitment to excellence for the residents they serve.
LITERACY DUPAGE
BRAND IDENTITY DESIGN, WEBSITE DESIGN/DEVELOPMENT
CLIENT TESTIMONIAL
“RVP gave Literacy DuPage more than a fresh, meaningful identity. Through conversation, collaboration, and creative iteration, they helped us clarify who we are and what we stand for—using both visual and verbal branding to set us apart and attract attention for our cause.”
— BETH NYLAND | Board Member, Marketing & Outreach Chair
MICHAEL VENICE, D.N.
BRAND IDENTITY DESIGN, WEBSITE DESIGN/DEVELOPMENT, MARKETING COMMUNICATIONS
CLIENT TESTIMONIAL
“Working with RVP has always been an efficient and enjoyable process. The firm created our brand identity and marketing communications and has recently completed design of our new website which very clearly explains the practice of Naprapathy and has become an important resource for our clients.”
— MICHAEL VENICE, D.N. | Doctor of Naprapathy
GOLAN CHRISTIE TAGLIA LLP
BRANDING, MARKETING COMMUNICATIONS, ADVERTISING, WEB DESIGN
Golan Christie Taglia LLP is a law firm dedicated to delivering successful results while providing their clients the highest levels of quality and personal service. GCT provides expertise in a broad array of practice areas and serves a wide variety of clients while consistently meeting their clients’ needs by maintaining a simple, yet effective philosophy: “Your Success. Our Focus.”
For more than 20 years, RVP assisted the firm in designing their brand and marketing communications programs and refreshing the GCT brand as they evolved and grew.
INDUCTOTHERM GROUP
MARKETING COMMUNICATIONS PROGRAM
Inductotherm Group leads the industry in the development and manufacturing of advanced technologies, products and systems for the heat-driven transformation of metals and specialty materials.
RVP collaborated with our partner, SpencerGrace, to elevate the design of the Steel brochure for print and digital, and communicate the importance of steel in bringing strength and structure to everyday life.
SENECAGLOBAL
BRAND IDENTITY DESIGN, WEBSITE DESIGN/DEVELOPMENT
SenecaGlobal is a trusted partner that helps clients leverage technology to achieve greater success through improved business performance and increased ROI. As a values-driven organization that creates deep partnerships with their clients, the firm focuses on their unique business and technology needs. Through their hybrid SmartSourcing delivery model, SenecaGlobal develops innovative solutions that make their clients’ lives easier, and ensures high quality and timely delivery, enabling them to take the organizations to new heights.
ISTHMUS PARTNERS
BRAND IDENTITY DESIGN, WEBSITE DESIGN/DEVELOPMENT, MARKETING COMMUNICATIONS
Isthmus Partners, LLC is an investment advisory firm that serves individuals and families, institutions, and financial advisors. Isthmus is a trusted partner in planning, executing and managing investments with disciplined methodologies and a proprietary processes that focus on high quality equities and independent valuations.
The new brand and communications were designed to showcase how Isthmus creates strong partnerships based on trust, and by aligning client goals with customized investment solutions that provide long-term growth and capital preservation.
THE NORA PROJECT ANNUAL REPORT
MARKETING COMMUNICATIONS
The Nora Project (TNP) is on a mission to promote disability inclusion by empowering educators and engaging students and communities. TNP trains and coaches educators and offers a suite of programs that dive deeply into the concepts of empathy and inclusion, explicitly addressing disability and difference as a part of human diversity. Their programs connect what students are learning to the real world, offering them authentic opportunities to practice what they learn during direct instruction.
SURGE INSTITUTE
WEBSITE DESIGN/DEVELOPMENT
Surge Institute is a movement that is changing the face of education leadership. More than 48% of school-aged children are black or brown, but just 17% of their teachers, 6% of their superintendents and 11% of their school board members look like them. This dearth of diverse leadership impacts decisions that affect kids and the communities in which they live.
The organization works to coach, enlighten and empower emerging leaders of color to fill the gap between communities and education leadership.
ANOTHER GENERATION ESTATE SALES
BRAND IDENTITY DESIGN, WEBSITE DESIGN/DEVELOPMENT, MARKETING COMMUNICATIONS
CLIENT TESTIMONIAL
“Robert Viola Partners created a dynamic brand, website and communications for Another Generation Estate Sales which helped tell our story clearly and concisely. Their consultation, design and marketing services have assisted us in creating greater awareness about our firm, which aided our growth and success.”
— CINDY SCHWERTFEGER | Owner
CURE | CITIZENS UNITED FOR RESEARCH IN EPILEPSY
MARKETING COMMUNICATIONS
Citizens United for Research in Epilepsy (CURE), is the leading nongovernmental agency fully committed to funding research in epilepsy. CURE’s mission is to cure epilepsy, transforming and saving millions of lives. The organization identifies and funds cutting-edge research, challenging scientists worldwide to collaborate and innovate in pursuit of this goal.